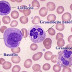

Páginas
▼
Mostrando entradas con la etiqueta citoplasma. Mostrar todas las entradas
Mostrando entradas con la etiqueta citoplasma. Mostrar todas las entradas
sábado, 21 de enero de 2012
viernes, 4 de noviembre de 2011
lunes, 24 de octubre de 2011
sábado, 22 de octubre de 2011
jueves, 3 de septiembre de 2009